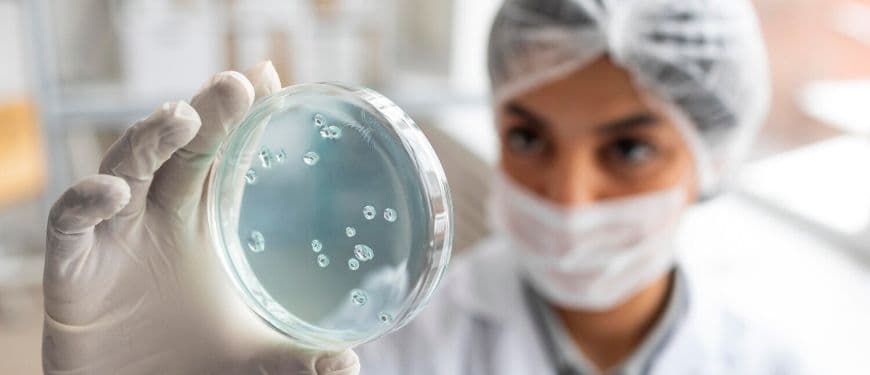
Article image

Ozempic es un fármaco para la diabetes tipo 2, que se ha convertido en el nuevo aliado del control de peso. Pero, ¿qué es exactamente Ozempic? Para los que no están familiarizados, es un medicamento que imita una hormona llamada GLP-1, la cual ayuda a regular el apetito y el azúcar en la sangre.
Este artículo desglosaremos cómo funciona Ozempic en el control de peso, por qué ha capturado la atención de tantos y cómo puede ser una herramienta útil en la lucha contra esos kilos de más. Así que, si estás buscando una solución que no implique pasar horas en el gimnasio o vivir a base de lechuga, sigue leyendo. ¡Te prometo que no mordemos!
El mecanismo de acción de Ozempic
¿Qué es el GLP-1?
Ozempic actúa imitando la acción del GLP-1, una hormona que se libera en el intestino después de comer. Esta hormona tiene múltiples funciones: aumenta la sensación de saciedad, reduce el apetito y ayuda a regular la insulina. En otras palabras, es como un pequeño guardián que se asegura de que no te excedas en la comida. Cuando tomas Ozempic, estás dándole un empujón a tu cuerpo para que se sienta satisfecho más rápido y, por ende, comes menos.
La relevancia de la saciedad
La saciedad es clave en cualquier plan de control de peso. Si te sientes lleno, es menos probable que busques ese snack extra a las 11 de la noche. Ozempic ayuda a prolongar esa sensación de plenitud, lo que significa que puedes disfrutar de tus comidas sin la ansiedad de querer comer más. Imagina ir a una cena y no sentir la necesidad de devorar todo lo que hay en la mesa. ¡Eso es lo que Ozempic puede hacer por ti!
Efectos en el metabolismo
Además de ayudar con la saciedad, Ozempic también tiene un impacto positivo en el metabolismo. Al regular los niveles de insulina, ayuda a tu cuerpo a utilizar mejor la glucosa, lo que puede resultar en una mayor quema de grasa. Esto es especialmente útil para aquellos que luchan con la resistencia a la insulina, un factor común en la obesidad. Así que, no solo estás comiendo menos, sino que tu cuerpo también está trabajando más eficientemente.
Beneficios adicionales de Ozempic
Control de la diabetes
Uno de los beneficios más destacados de Ozempic es su capacidad para ayudar a controlar los niveles de azúcar en la sangre. Esto es especialmente relevante para quienes tienen diabetes tipo 2. Al regular la insulina y el azúcar, no solo se pierde peso, sino que también se mejora la salud general. Es como dos pájaros de un tiro: controlas tu peso y tu diabetes al mismo tiempo.
Mejora en la calidad de vida
Perder peso puede ser un desafío, pero también puede mejorar tu calidad de vida. Con Ozempic, muchos usuarios reportan no solo una pérdida de peso, sino también un aumento en la energía y una mejor salud en general. Menos peso significa menos presión en las articulaciones, mejor movilidad y, en general, una vida más activa. ¡Adiós a la fatiga y hola a la vitalidad!
Efectos secundarios y consideraciones
Como cualquier medicamento, Ozempic no está exento de efectos secundarios. Algunos usuarios pueden experimentar náuseas, vómitos o diarrea, especialmente al comenzar el tratamiento. Es importante hablar con un médico antes de iniciar cualquier tratamiento para asegurarse de que sea adecuado para ti. Además, no es una solución mágica; debe complementarse con una dieta equilibrada y ejercicio.
Cómo incorporar Ozempic en tu rutina

Consulta a un profesional de la salud
Antes de lanzarte a la aventura de Ozempic, es importante que hables con un médico. Ellos pueden evaluar tu situación y determinar si este medicamento es adecuado para ti. No todos los cuerpos son iguales, y lo que funciona para uno puede no funcionar para otro.
Establece metas realistas
Si decides probar Ozempic, establece metas alcanzables. No esperes perder 10 kilos en una semana. La pérdida de peso saludable es un proceso gradual. Con la ayuda de Ozempic, puedes lograrlo, pero la paciencia es clave. ¡Recuerda que Roma no se construyó en un día!
Complementa con hábitos saludables
Ozempic no es una varita mágica. Para obtener los mejores resultados, combina su uso con una dieta equilibrada y ejercicio regular. Piensa en ello como un equipo de ensueño: tú, Ozempic y un estilo de vida saludable. Juntos, pueden hacer maravillas.
Testimonios de usuarios
Historias de éxito
No hay nada más motivador que escuchar historias de quienes han probado Ozempic y han visto resultados. Muchos usuarios reportan no solo pérdida de peso, sino también un cambio en su relación con la comida. Algunos han dejado de ver la comida como un enemigo y han aprendido a disfrutar de sus comidas de manera más consciente.
La comunidad de apoyo
Además de los testimonios individuales, hay una comunidad creciente de personas que comparten sus experiencias con Ozempic. Grupos en redes sociales y foros en línea ofrecen un espacio para compartir consejos, recetas y motivación. No subestimes el poder de una buena comunidad; puede ser el empujón que necesitas para seguir adelante.
Lo que dicen los expertos
Los profesionales de la salud también han comenzado a reconocer los beneficios de Ozempic en el control de peso. Sin embargo, endocrinólogos y nutricionistas siempre enfatizan la importancia de un enfoque integral que incluya cambios en el estilo de vida.
Ozempic se presenta como una opción interesante para quienes buscan controlar su peso de manera efectiva. No solo ayuda a reducir el apetito y mejora la regulación del azúcar en la sangre, sino que también puede transformar la calidad de vida de quienes lo utilizan. Si bien no es una solución mágica, su combinación con hábitos saludables puede llevar a resultados sorprendentes. Así que, si estás listo para darle una oportunidad, ¡adelante! Tu viaje hacia un estilo de vida más saludable podría estar a solo una inyección de distancia.